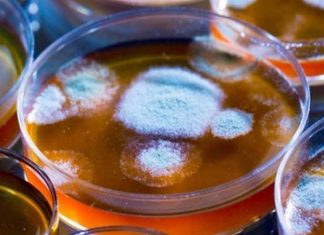
‘Trojan horse’ antibiotic could help combat superbugs, finds new research 'Trojan horse' antibiotic could help combat superbugs, finds new research

Katherine Langford Joins ‘Avengers 4’ (Reports)
13 Reasons Why breakout Katherine Langford joined Marvel Studios’ Avengers 4 in an unknown role, it was revealed Friday.
As confirmed by The Wrap, the...
Magna Carta theft: Man ‘armed with hammer tries to steal manuscript
A 45-year-old man has been arrested on suspicion of the attempted theft of the Magna Carta from Salisbury Cathedral.
Wiltshire Police said shortly before 5pm...
Same-sex penguin couple welcomes foster penguin chick (Picture)
A pair of gay penguins at Sydney Sea Life Aquarium have become "doting" parents after their foster egg hatched.
The same-sex couple, Sphen and Magic,...
Cory Booker and James Clapper bombs: two more packages suspected
One was addressed to Sen. Cory Booker (D-N.J.) and the other to James Clapper, the former director of national intelligence, and was to be...
Frontier Airlines: Passenger manages to open door while plane (Picture)
A passenger was escorted off a Frontier Airlines flight from Cancun to St. Louis that was eventually suspended after an onboard disturbance Monday, according...
‘Trojan horse’ antibiotic could help combat superbugs, finds new research
Scientists say they have engineered a new antibiotic that appears promising in early clinical trials.
The drug, made by Shionogi Inc, acts like the Trojan...
AI-generated portrait just sold at auction for $432K, Report
AI-generated artwork Portrait of Edmond Belamy sold for 45 times its anticipated price at Christie's, going under the hammer for an eye-watering $435,000 in...
Queen Elizabeth corgis dies, ending her 74 year connection with the...
Queen Elizabeth sadly had to say goodbye to her last corgi, Whisper, who reportedly died a week ago.
The Queen had adopted "friendly chap" Whisper,...
Saudi Arabian say Jamal Khashoggi’s killing was planned
Journalist Jamal Khashoggi's murder was "premeditated", Saudi Arabia's public prosecutor has been quoted as saying by Saudi state media.
The evidence for this came from...
Sofia Vergara tops Forbes’ highest-paid TV actresses list , Report
Sofia Vergara is once again the belle of the TV-actress-salary ball, having been named No. 1 on Forbes’ list of the World’s Highest-Paid Actresses...
100-times-faster internet speed by harnessing twisted light
Australian scientists have created a device which can increase the speed of the internet by up to 100 times by harnessing twisted light beams...
Jesus painting survives fire that decimated historic church
The heat from the massive fire that destroyed First Baptist Church in Wakefield, Massachusetts, on Tuesday night could be felt from several streets away,...